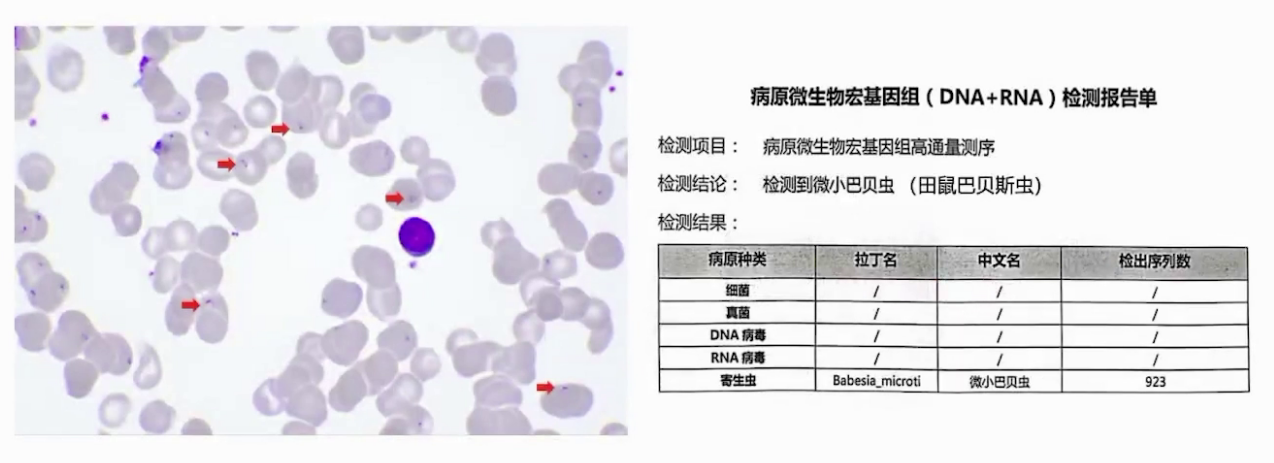
图片 5.png
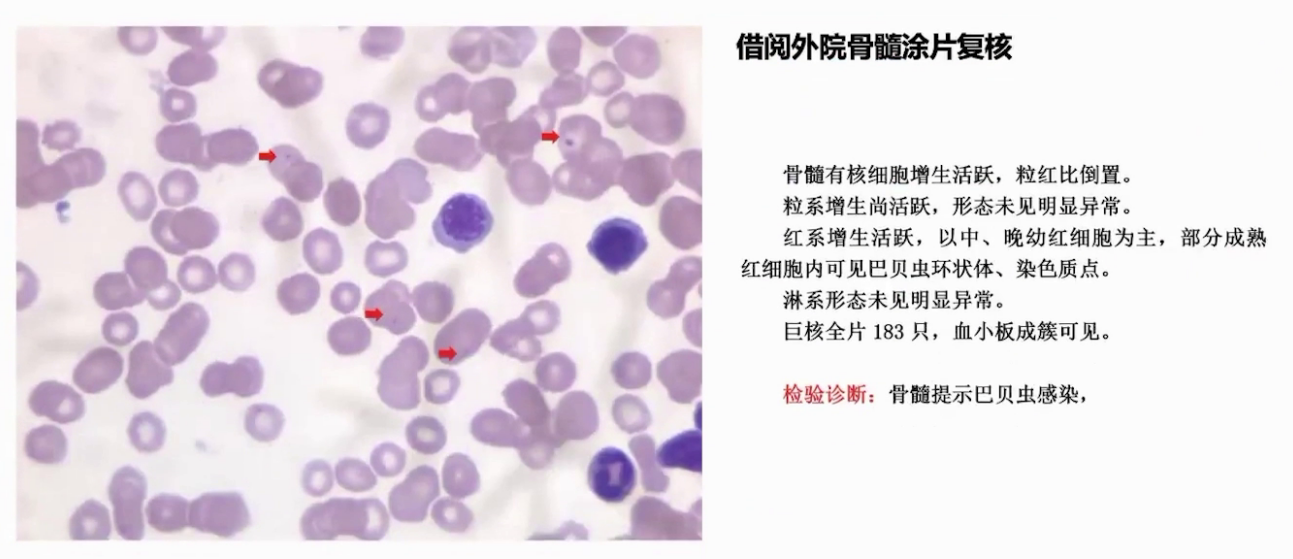
图片 6.png
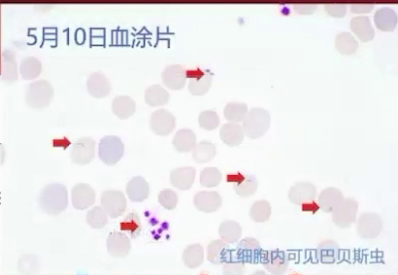
图片 8.png

查看更多
密码过期或已经不安全,请修改密码
修改密码
壹生身份认证协议书
同意
拒绝
同意
拒绝
同意
不同意并跳过
现病史
3月女性儿童,主诉面色苍白3周余。
患儿3周余前“感冒”后出现面色苍白,发热1次,38.6℃, 伴有咳嗽,阵发性连声咳。胃纳减少,奶量约平日一半,伴吐奶3-4次/天,当地医院就诊血常规结果示血红蛋白55g/L, 遂转入当地儿童医院住院诊治。当地医院诊断为自身免疫性溶血性贫血、支气管肺炎、房间隔缺损,给予地塞米松、IVIG、红细胞悬液输注及头孢噻肟抗感染治疗,但血红蛋白不稳定,治疗效果不佳,遂转至我院。
既往史、个人史、家族史
无特殊。
辅助检查
(1)体格检查
当地医院:患儿精神萎软,呈重度贫血貌,心肺听诊及腹部查体无特殊。
本院:肝脏肋下2厘米,脾脏肋下3厘米。
(2)实验室检查
当地医院:血常规示血红蛋白45g/L,正细胞正色素性,网织红细胞比例18.71%;血生化总胆红素升高,以间接胆红素为主;外周血涂片红细胞中空大小不一;骨髓涂片、铁代谢等多项检查无明显异常;病原学检查EB病毒IgG阳性,其余阴性。

本院:血红蛋白55g/L,网织红细胞25%,血生化胆红素升高,以间接胆红素为主,乳酸脱氢酶1801U/L。Coombs直接试验阴性。
(3)影像学检查
当地医院:
1)超声心动图:房间隔缺损;
2)胸部CT:两肺感染;
3)腹部B超:无明显异常。
本院:
1)腹部B超:肝脏肋下2cm、剑突下3cm,脾脏肋下3cm;
2)上腹部CT:肝脾肿大;
3)胸部CT:两肺条索灶及磨玻璃样影;
4)颈部、下腹部CT:无明显异常。
初步诊断
1、溶血性贫血;2、自身免疫性溶血性贫血?
诊疗过程
(1)自身免疫性溶血性贫血诊断存疑
我院复查Coombs直接试验阴性,与当地结果不符。
(2)糖皮质激素观察疗效,同时进一步检查
1)考虑红细胞形态变化对贫血诊断意义,先进行第三次血涂片检查,发现红细胞内环状体和小体,宏基因检测证实为微小巴贝虫感染。
2)借阅外院骨髓涂片复核也提示巴贝虫感染。
3)最终诊断:巴贝斯虫病。
(3)明确诊断后,停用激素,先予阿奇霉素单药治疗,后联用阿托伐醌(20mg/kg,q12h 口服满 10 天)
1)治疗后血红蛋白恢复,网织红细胞下降,外周血中巴贝斯虫数量减少。

2)患儿出院,门诊继续口服阿托伐醌满疗程,复查各项指标正常。
1、贫血诊断流程

2、贫血分类

3、溶血性贫血成因剖析


1、疾病特点
(1)概述:巴贝斯虫病是由巴贝虫属红细胞原虫引起的传染病,传染源包括感染的人和多种动物,传播途径主要为蜱叮咬、输血或器官移植,人普遍易感。
(2)临床表现:潜伏期蜱叮咬后1-6周,输血后1-6个月。多数患者有间歇性高热、畏寒等症状,免疫低下及输血感染者可出现严重并发症,重症死亡率达20%。
(3)实验室检查:可见溶血性贫血、血小板减少、肝酶升高等。
(4)诊断:依靠外周血或骨髓涂片及巴贝斯虫DNA PCR检测。血涂片对可疑患者重要,但病程早期需重复检测。
2、诊断流程

3、治疗

查看更多